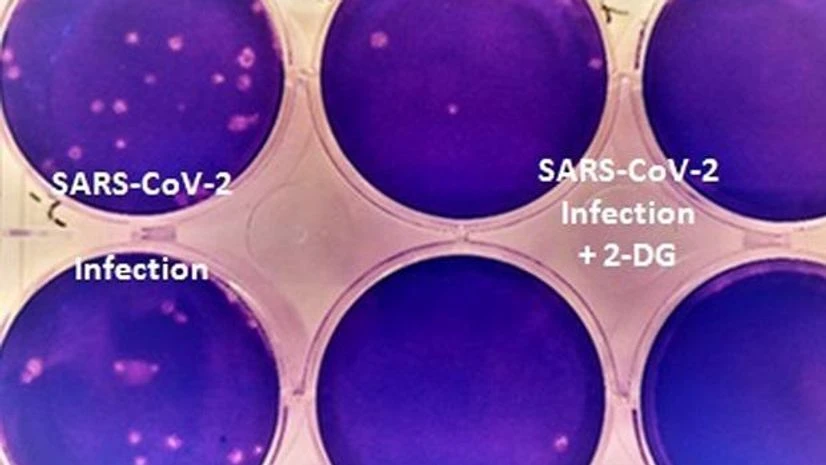
DRDO Covid drug DRDO Covid drug

The Defence Research and Development Organisation's (DRDO) new anti-COVID drug 2-DG should work against various strains of the COVID-19 virus, DRDO chairperson Dr G Satheesh Reddy said on Monday.
"The drug 2DG developed by us should work against the various strains of the COVID-19 virus," Reddy told ANI when asked if the drug would be effective against the new strains and other mutated variants of the COVId-19 virus.
He added that the organisation was hoping to ramp up production of the drug up to one lakh sachet per day by the first week of June.
"From the first week of June, we are hoping to ramp up the production of the drug as the process to develop it takes around one month. We are hoping to increase the number of sachets production to one lakh per day," Reddy said.
The first batch of anti-COVID drug was released by Defence Minister Rajnath Singh and union health minister Harsh Vardhan on Monday.
Also Read
Earlier, the Chairperson had informed that the first batch of anti-COVID drug would only be available only to AIIMS, Armed Forces Hospitals, DRDO hospitals and other places in need. It will be made available to other hospitals in June.
India on Monday reported 2,81,386 new COVID-19 cases, 3,78,741 discharges and 4,106 deaths in the last 24 hours, as per Union Health Ministry
The total cases in the country stands at 2,49,65,463, including 2,11,74,076 recoveries and 2,74,390 reported deaths. There are currently 35,16,997 active cases.
(Only the headline and picture of this report may have been reworked by the Business Standard staff; the rest of the content is auto-generated from a syndicated feed.)
)
